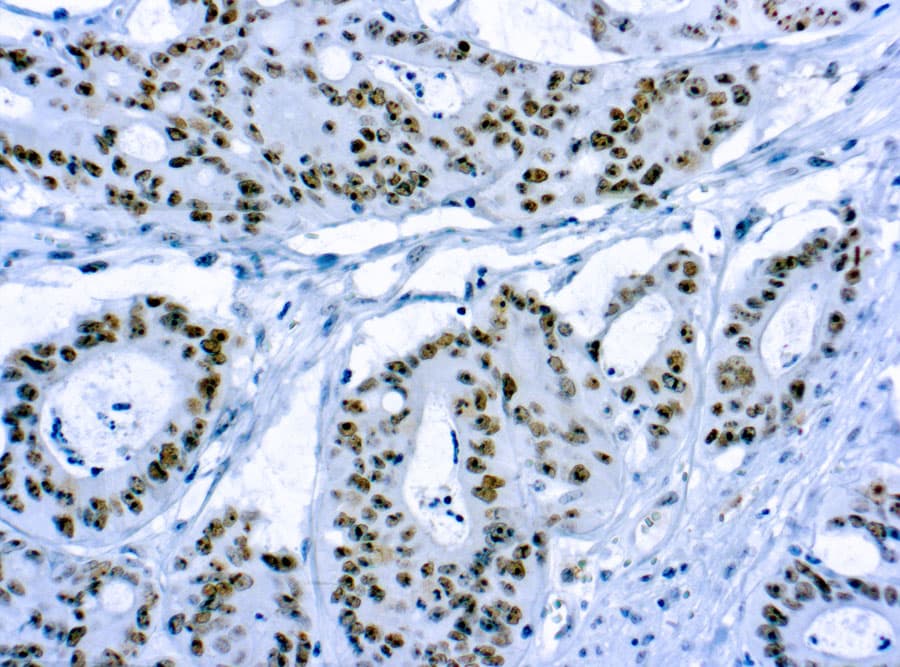
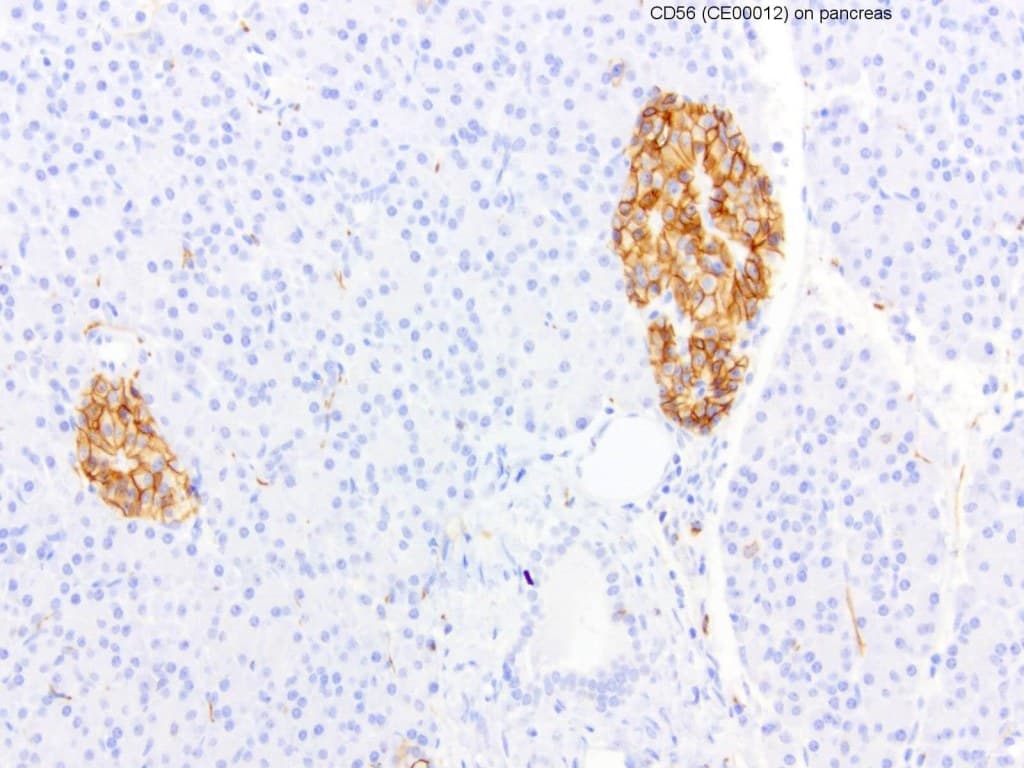

Les anticorps Anti-CD56 (molécule d’adhésion cellulaire neuronale, NCAM) CE/IVD pour immunohistochimie (IHC) permettent une détection fiable de CD56 dans les tissus fixés au formol et inclus en paraffine (FFPE), facilitant un immunophénotypage précis en hématopathologie. CD56 est une glycoprotéine transmembranaire de la superfamille des immunoglobulines, avec plusieurs isoformes (NCAM 120, NCAM 140, NCAM 180) qui diffèrent par la longueur de leur domaine intracellulaire et leur distribution tissulaire. Elle est principalement exprimée par les cellules NK et certaines sous-populations de lymphocytes T, avec également une expression observée dans certains types cellulaires néoplasiques.
Signification biologique
- Adhésion cellulaire et signalisation : CD56 régule les interactions homophiles et hétérophiles qui influencent l’adhésion, la migration et la signalisation intracellulaire, pertinentes à la biologie neuronale et hématopoïétique.
- Expression dans le système immunitaire : Son expression élevée sur les cellules NK et certains lymphocytes T activés reflète des fonctions cytotoxiques et de surveillance immunitaire.
Utilité diagnostique en hématopathologie
- Lymphomes à cellules NK et néoplasmes associés : L’IHC CD56 constitue un marqueur clé pour une classification précise.
- Pathologies des plasmocytes : Une expression anormale de CD56 dans le myélome multiple aide à confirmer la prolifération clonale des plasmocytes et peut être corrélée à des paramètres cliniques ou pronostiques.
- Sous-typage des leucémies : Observée dans certains sous-types de leucémie myéloïde aiguë, elle aide à la sous-classification lorsqu’elle est utilisée en combinaison avec la morphologie et d’autres marqueurs immunophénotypiques.
Principales caractéristiques des anticorps Anti-CD56 CE/IVD
- Validation clinique : Optimisés pour les flux de travail diagnostiques régulés sur échantillons FFPE en hématopathologie.
- Haute spécificité : Les anticorps monoclonaux garantissent une détection reproductible avec une réactivité croisée minimale.
- Compatibilité avec plateformes automatisées : Adaptés aux protocoles standardisés sur systèmes IHC automatisés.
- Intégration dans des panels : Complètent les panels d’immunophénotypage pour améliorer la précision diagnostique.